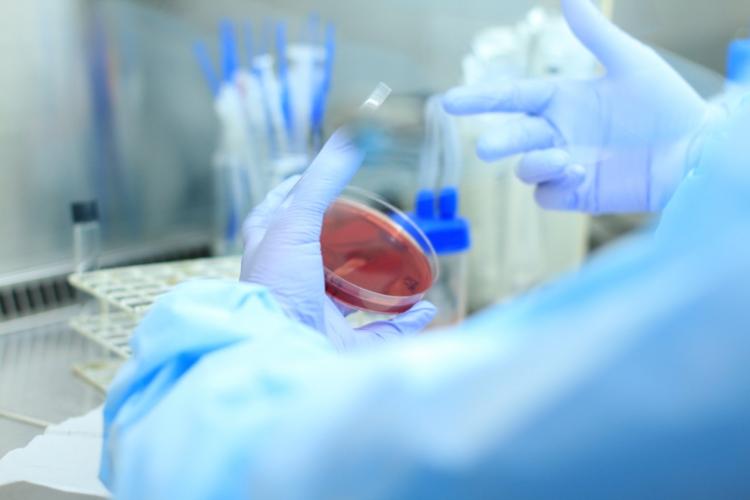
Laboratório do Huop aumentou em 40% o número de exames realizados

Laboratório do Huop aumentou em 40% o número de exames realizados 17/07/2020 - 13:34
A ampliação do número de leitos no Hospital Universitário do Oeste do Paraná (Huop), em razão da pandemia da Covid-19, resultou também em aumento no número de exames realizados pelo Laboratório de Análises Clínicas da instituição. Apenas em junho desse ano foram realizados 53.250 mil exames, um acréscimo de cerca de 40% se comparado a junho de 2019, quando foram realizados 36.220. “Isso se deve ao aumento do número de leitos, exclusivos para Covid-19, que impacta em todos os setores do hospital”, afirma o coordenador do Laboratório, Muriel Padovani. A capacidade de leitos no Huop foi ampliada em mais 30 leitos de UTI (Unidade de Terapia Intensiva) e 27 leitos de enfermaria, totalizando 295 leitos.
Os exames que demandam um número maior nesse período são os que demonstram os marcadores de inflamação, marcadores cardíacos, e marcadores de coagulação, realizados diariamente na Ala Covid-19. “Esse perfil de exames dá suporte para decisões clínicas. Os pacientes dessa unidade têm uma rotina preconizada pela equipe médica, e devido à gravidade, os exames são processados de maneira prioritária para que as decisões clínicas sejam o mais eficiente possível”, explica Muriel.
Com o aumento dos exames, o setor conquistou também outros equipamentos que dão suporte à equipe nesse momento. “Prevíamos o aumento dessa demanda e por isso, ampliamos a capacidade de equipamento para absorver isso, como a aquisição do terceiro gasômetro, que é essencial para pacientes internados na Unidade de Terapia Intensiva (UTI)”, diz. “É um empenho de toda equipe, que é extremamente qualificada, para suprir essa demanda de exames, fundamentais para as decisões clínicas”, complementa Muriel.
O diretor administrativo do Huop, Rodrigo Barcella, também enfatiza a importância dos exames nesse momento. “O aumento do volume de exames laboratoriais é reflexo do arsenal completo que conseguimos dispor para o melhor tipo de atendimento, e, para os pacientes com a Covid-19 não poderia ser diferente. Os exames são essenciais para auxiliar o diagnóstico e tratamento da doença, que é nova e de certa forma enigmática diante da comunidade científica”, conclui.